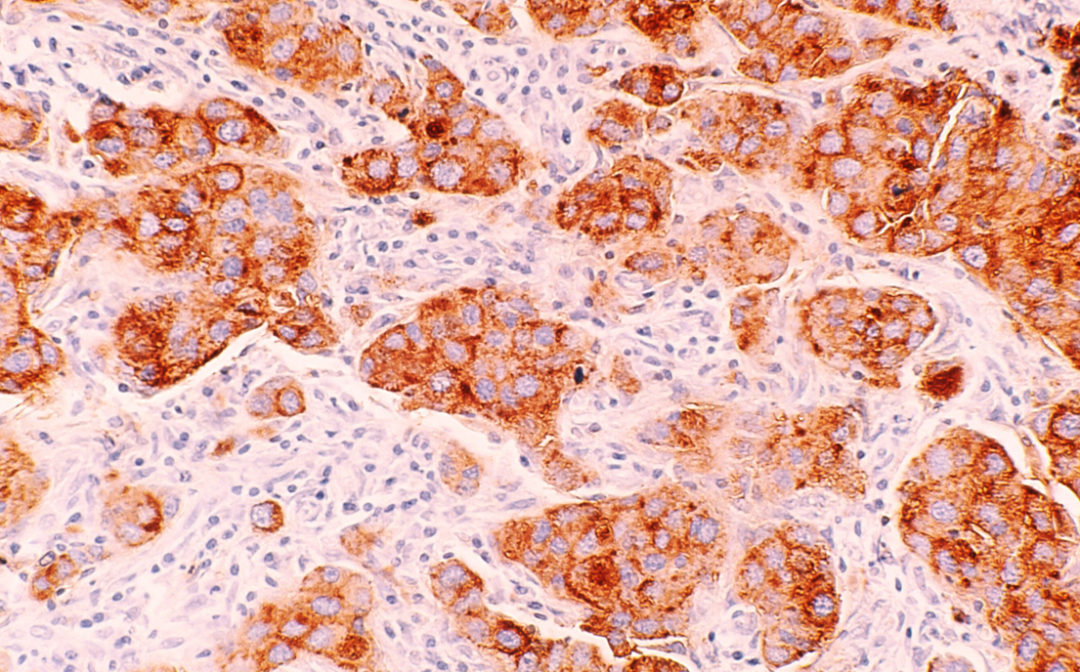
【Science子刊】康奈尔团队发现BMI升高造成乳腺细胞更多DNA损伤，增加乳腺癌患病风险！

用户登录转化医学是什么?
推荐活动


【直播】Twist 寡核苷酸池在生命科学中的创新应用:FOCAS--解析癌症中m6A修饰位点的全转录组功能
专家访谈
热门活动
分享至:

-
 第二届中国类器官转化医学大会2025-11-14
第二届中国类器官转化医学大会2025-11-14 -
 第六届单细胞技术应用研讨会暨空间组学前沿研讨会2025-09-19
第六届单细胞技术应用研讨会暨空间组学前沿研讨会2025-09-19 -
 第七届上海国际癌症大会2025-06-12
第七届上海国际癌症大会2025-06-12 -
 中国转化医学产业大会 大咖论坛2025-02-27
中国转化医学产业大会 大咖论坛2025-02-27 -
-
【直播】Twist 寡核苷酸池在生命科学中的创新应用:FOCAS--解析癌症中m6A修饰位点的全转录组功能
-
Cell Stem Cell | 复旦大学附属肿瘤医院郭小毛/俞晓立/陈飞/沈敏洪团队合作构建乳腺癌类器官多组学图谱,解析四种表观状态,揭示驱动乳腺癌淋巴结转移的关键转录因子
-
湖南省肿瘤医院/中南大学湘雅医学院附属肿瘤医院等单位合作发文:靶向化疗耐药性的新靶点
-
鲲羽生物您共赴第五届长三角单细胞与空间组学大会,开春生命科学盛会,不见不散!
-
爱博泰克邀您共赴第五届长三角单细胞与空间组学大会,开春生命科学盛会,不见不散!
-
百趣生物邀您共赴第五届长三角单细胞与空间组学大会,开春生命科学盛会,不见不散!
-
倒计时7天!第五届长三角单细胞与空间组学论坛3月19-20日上海举办,顶尖专家齐聚,共绘科研与临床转化新蓝图,邀您共赴盛宴!
-
促进铁死亡!浙江大学/耶鲁大学合作发文:一种重要的抗肿瘤机制
-
Cell | 中南大学湘雅医院李吉/邓智利&山东大学孙金鹏/郭璐璐团队揭示玫瑰痤疮红斑代谢调控新机制,并开发新型靶向激动剂
-
实践医学邀您共赴第五届长三角单细胞与空间组学大会,开春生命科学盛会,不见不散!
最新原创
-
科研速递网络研讨会|Twist 寡核苷酸池在生命科学中的创新应用:FOCAS--解析癌症中m6A修饰位点的全转录组功能
-
【直播】Twist 寡核苷酸池在生命科学中的创新应用:FOCAS--解析癌症中m6A修饰位点的全转录组功能
-
氘峰医疗邀您共赴第五届长三角单细胞与空间组学大会,开春生命科学盛会,不见不散!
-
【参会提醒】第五届长三角单细胞与空间组学论坛3月19-20日上海举办,顶尖专家齐聚,共绘科研与临床转化新蓝图,邀您共赴盛宴!
-
基因汇邀您共赴第五届长三角单细胞与空间组学大会,开春生命科学盛会,不见不散!
-
Cell Stem Cell | 复旦大学附属肿瘤医院郭小毛/俞晓立/陈飞/沈敏洪团队合作构建乳腺癌类器官多组学图谱,解析四种表观状态,揭示驱动乳腺癌淋巴结转移的关键转录因子
-
爱博泰克邀您共赴第五届长三角单细胞与空间组学大会,开春生命科学盛会,不见不散!
-
悌可光电邀您共赴第五届长三角单细胞与空间组学大会,开春生命科学盛会,不见不散!
-
促进铁死亡!浙江大学/耶鲁大学合作发文:一种重要的抗肿瘤机制
-
Cell | 天津医科大学王霆/傅源/向嵩&电子科技大学余秋景团队发现线粒体NAD+水解的关键酶,系统揭示其分子机制
快捷导航
热门标签
订阅Newsletter
提交您的邮箱地址,我们会定期将电子期刊发送到您的邮箱
 腾讯登录
腾讯登录